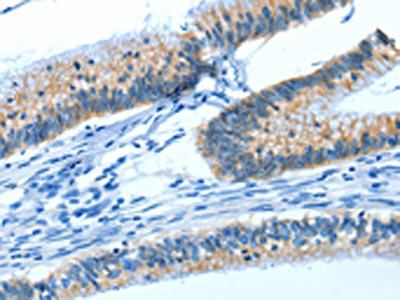

-
中文名稱:ATP1A1兔多克隆抗體
-
貨號:CSB-PA695367
-
規格:¥1100
-
圖片:
-
The image on the left is immunohistochemistry of paraffin-embedded Human cervical cancer tissue using CSB-PA695367(ATP1A1 Antibody) at dilution 1/35, on the right is treated with synthetic peptide. (Original magnification: ×200)
-
The image on the left is immunohistochemistry of paraffin-embedded Human colon cancer tissue using CSB-PA695367(ATP1A1 Antibody) at dilution 1/35, on the right is treated with synthetic peptide. (Original magnification: ×200)
-
-
其他:
產品詳情
-
Uniprot No.:
-
基因名:
-
別名:A1A1 antibody; AT1A1 antibody; AT1A1_HUMAN antibody; ATP1A1 antibody; Atpa-1 antibody; ATPase Na+/K+ transporting alpha 1 polypeptide antibody; ATPase Na+/K+ transporting subunit alpha 1 antibody; BC010319 antibody; EC 3.6.3.9 antibody; MGC3285 antibody; MGC38419 antibody; MGC51750 antibody; Na K ATPase alpha A catalytic polypeptide antibody; Na K ATPase catalytic subunit alpha A protein antibody; Na(+)/K(+) ATPase 1 antibody; Na(+)/K(+) ATPase alpha-1 subunit antibody; Na+; K+ ATPase alpha subunit antibody; Na+/K+ ATPase alpha 1 subunit antibody; Na+/K+ ATPase 1 antibody; Na,K ATPase alpha 1 subunit antibody; Nkaa1b antibody; Sodium potassium ATPase alpha 1 polypeptide antibody; Sodium pump 1 antibody; Sodium pump subunit alpha-1 antibody; sodium-potassium ATPase catalytic subunit alpha-1 antibody; Sodium/potassium-transporting ATPase subunit alpha-1 antibody
-
宿主:Rabbit
-
反應種屬:Human,Mouse,Rat
-
免疫原:Synthetic peptide of Human ATP1A1
-
免疫原種屬:Homo sapiens (Human)
-
標記方式:Non-conjugated
-
抗體亞型:IgG
-
純化方式:Antigen affinity purification
-
濃度:It differs from different batches. Please contact us to confirm it.
-
保存緩沖液:-20°C, pH7.4 PBS, 0.05% NaN3, 40% Glycerol
-
產品提供形式:Liquid
-
應用范圍:ELISA,IHC
-
推薦稀釋比:
Application Recommended Dilution ELISA 1:1000-1:5000 IHC 1:25-1:100 -
Protocols:
-
儲存條件:Upon receipt, store at -20°C or -80°C. Avoid repeated freeze.
-
貨期:Basically, we can dispatch the products out in 1-3 working days after receiving your orders. Delivery time maybe differs from different purchasing way or location, please kindly consult your local distributors for specific delivery time.
-
用途:For Research Use Only. Not for use in diagnostic or therapeutic procedures.
相關產品
靶點詳情
-
功能:This is the catalytic component of the active enzyme, which catalyzes the hydrolysis of ATP coupled with the exchange of sodium and potassium ions across the plasma membrane. This action creates the electrochemical gradient of sodium and potassium ions, providing the energy for active transport of various nutrients.
-
基因功能參考文獻:
- mutations in ATP1A1, which encodes the alpha1 subunit of the Na(+),K(+)-ATPase, are identified as a cause of autosomal-dominant CMT2. PMID: 29499166
- Low ATP1A1 expression is associated with renal cell carcinoma. PMID: 30015972
- These data suggest the role of beta-amyloid as a novel physiological regulator of Na,K-ATPase. PMID: 27296892
- induction of a novel pathway (alpha1-AMPK-ULK1) induces autophagy as a host-directed strategy for HCMV inhibition.IMPORTANCE PMID: 29321306
- An antibody against the extracellular DR region (897-911) of Na(+)-K(+)-ATPase subunit alpha 1 disrupted the Na+-K+-ATPase/ROS amplifier and protected cultured cardiomyocytes from ROS-induced injury. PMID: 28181111
- Disruption of Ankyrin B and Caveolin-1 Interaction Sites Alters Na(+),K(+)-ATPase Membrane Diffusion PMID: 28988699
- Mutations in ATP1A1 cause the excessive autonomous aldosterone secretion of Aldosterone-producing Adenomas. PMID: 28584016
- Cardiotonic steroids activate NF-kappaB leading to proinflammatory cytokine production in primary macrophages through a signaling complex, including CD36, TLR4, and Na/K-ATPase. PMID: 28619997
- This study reports molecular dynamic simulations of the human NaK-ATPase alpha1 beta 1 isoform embedded into 1,2-oleoylphosphatidylcholine bilayer. PMID: 27966362
- Data show that the expression of aquaporin (AQP) 1, AQP3, AQP5, epithelial Na+ channel (ENaC) and sodium potassium ATPase (Na-K-ATPase) are altered in patients with acute respiratory failure (ARF) due to diffuse alveolar damage (DAD), and the cause of DAD does not seem to influence the level of impairment of these channels. PMID: 27835672
- Ouabain stimulates NKA in renal proximal tubule cells through an angiotensin/AT1R-dependent mechanism and that this pathway contributes to cardiac glycoside associated hypertension. PMID: 27496272
- Reduction in ATP1A1 expression levels is related to major depressive disorder anxiety score. PMID: 27487491
- Our current findings demonstrate that Arctigenin is an antagonist of MR and effectively decreases the Na/K-ATPase 1 gene expression. Our work provides a hint for the drug discovery against cardiovascular disease PMID: 26446917
- Data suggest that targeting Na(+)/K(+) ATPase alpha-1 subunit (ATP1A1) is a approach to the treatment of hepatocellular carcinoma (HCC). PMID: 26334094
- Mutations in ATP1A1 gene is associated with aldosterone-producing adenomas. PMID: 26285814
- Gal-3 interacts with ATP1A1 and induces the phosphorylation of MDR1, mediating multidrug resistance. PMID: 26158764
- protein kinase A and C activation can increase Na,K-ATPase activity in human muscle but not via P2Y receptor stimulation. PMID: 24614174
- Mutations of the ATP1A1 depolarize adrenocortical cells, disturb the K+ sensitivity, and lower intracellular pH but do not induce an overt increase of intracellular Ca2+. PMID: 26418325
- Different mutations (KCNJ5, ATP1A1, ATP2B3, and CACNA1D) are found in different aldosterone-producing nodules from the same adrenal, suggesting that somatic mutations are independent events triggered by mechanisms that remain to be identified. PMID: 26351028
- Data shows that a functional 12T-insertion polymorphism in the ATP1A1 promoter confers decreased susceptibility to hypertension in a male Sardinian population supporting ATP1A1 as a hypertension susceptibility gene in this population. PMID: 25615575
- Data show that the intracellular M4M5 loop of human alpha1 subunit of Na+,K+-ATPase (ATP1a1) interacts directly with rat rab GTP-binding protein Rab27a. PMID: 25051489
- Ebola VP24 protein plays a critical role in the evasion of the host immune response by interacting with human ATP1a1 protein. PMID: 25158218
- Studies indicate specific lipid-binding sites in Na,K-ATPase E1 and E2 crystal structures. PMID: 25791351
- Report tumor cell sensitivity to cardiac glycosides depends on pattern of expression of alpha1-, alpha2-, or alpha3-isoforms of Na-K-ATPase. PMID: 25994790
- ATP1A1-mediated Src signaling inhibits coronavirus entry into host cells. PMID: 25653449
- The cytoplasmic domain of ATP1A1 directly interacts with FGF2 and is required for FGF2 secretion. PMID: 25533462
- While JNK exerts an inhibitory effect on the ATPase, NF-kappaB increases its activity and abrogates the stimulatory effect of the sphingolipid on JNK leading thus to an additional increase in the ATPase activity. PMID: 24819540
- Somatic mutations found in KCNJ5, ATP1A1, and ATP2B3 appear to be the driving forces for a higher aldosterone production and proliferations of glomerulosa cells. PMID: 24179102
- H-K-ATPase alpha-subunit mRNA 3' UTR to binding of miR-1289 identifies a novel regulatory mechanism of gastric acid secretion and offers new insights into mechanisms underlying transient H. pylori-induced hypochlorhydria. PMID: 24503769
- JAK2 is a novel energy-sensing kinase that curtails energy consumption by downregulating Na(+)/K(+)-ATPase expression and activity. PMID: 24304834
- Data indicate that overexpression of ouabain-insensitive rat Na(+)/K(+)-ATPase alpha1 failed to inhibit internalization of human Na(+)/K(+)-ATPase alpha1 expressed in the same cells. PMID: 24275648
- ATP1A1 mutations are present in aldosterone-producing adenomas that result in an increase in CYP11B2 gene expression and may account for the dysregulated aldosterone production in a subset of patients with sporadic primary aldosteronism. PMID: 24082052
- Somatic mutations in either ATP1A1 and CACNA1D were found in a subset of adrenal aldosterone-producing adenomas with a zona glomerulosa-like phenotype. PMID: 23913004
- Evidence for a new mechanism by which hypercapnia via soluble adenylyl cyclase, cAMP, PKA Type Ialpha, and alpha-adducin regulates Na,K-ATPase endocytosis in alveolar epithelial cells. PMID: 23349050
- Somatic mutations in ATP1A1 gene leads to aldosterone-producing adenomas and secondary hypertension. PMID: 23416519
- ZNRF1 and ZNRF2 are new players in regulation of the ubiquitous Na(+)/K(+)ATPase that is tuned to changing demands in many physiological contexts. PMID: 22797923
- NRF-1 regulates Atp1a1 and Atp1b1 and are important in mediating the energy generation and neuronal activity. PMID: 23048038
- Ouabain could up-regulate Na+, K(+)-ATPase alpha1 subunit expression and reduce beta1-subunit expression which mediated signal transduction and decreased cell-cell adhesions and induced ECV304 cell death. PMID: 21141520
- Data show that Na(+),K(+)-ATPase activity was >50% lower and membrane-associated tubulin content was >200% higher in erythrocyte membranes from diabetic patients. PMID: 22565168
- A significant increase in the expression of ATP1A1, which encodes the alpha1-subunit of the Na(+)/K(+)-ATPase, was identified in HNF1B patients consistent with its role in Mg(2+) homeostasis. PMID: 22269832
- the sodium pump alpha1 sub-unit has a role in progression of metastatic melanoma PMID: 19243476
- FXYD1 raises the affinity of the human alpha1beta1 isoform of Na,K-ATPase for Na ions PMID: 21449573
- There was overexpression of the alpha1 or alpha3 NaK subunits in more than half of the medulloblastomas. PMID: 21498719
- The increased maternal AChE and Na(+), K(+)-ATPase activities may be due to the low total antioxidant status determined post vaginal delivery, whereas their decreased activities in prematures to their immaturity. PMID: 20964587
- Studies indicate that change of Na,K-ATPase activity can influence neurotransmitter release. PMID: 21043236
- Observational study of gene-disease association, gene-environment interaction, and pharmacogenomic / toxicogenomic. (HuGE Navigator) PMID: 20628086
- Silencing ATP1A1 inhibits the proliferation of HepG2 cells by decreasing the expression of MAPK1 and induces cell cycle arrest. PMID: 20450619
- Results suggest that the association of NHE-1 with Na-K-ATPase is critical for ouabain-mediated regulation of Na-K-ATPase and that these effects may play a role in cardioglycoside-stimulated hypertension. PMID: 20427472
- These results suggest that Akt plays a major role in Na(+)/K(+)-ATPase intracellular translocation and thus in alveolar fluid reabsorption. PMID: 20332111
- Data conclude that human proximal tubular cells respond to a hyperosmotic challenge with an increase in FXYD2 and Na,K-ATPase protein expression, though to a smaller absolute extent in patient cells. PMID: 19865785
顯示更多
收起更多
-
亞細胞定位:Basolateral cell membrane; Multi-pass membrane protein. Cell membrane, sarcolemma; Multi-pass membrane protein. Cell projection, axon. Melanosome.
-
蛋白家族:Cation transport ATPase (P-type) (TC 3.A.3) family, Type IIC subfamily
-
數據庫鏈接:
Most popular with customers
-
-
YWHAB Recombinant Monoclonal Antibody
Applications: ELISA, WB, IHC, IF, FC
Species Reactivity: Human, Mouse, Rat
-
Phospho-YAP1 (S127) Recombinant Monoclonal Antibody
Applications: ELISA, WB, IHC
Species Reactivity: Human
-
-
-
-
-